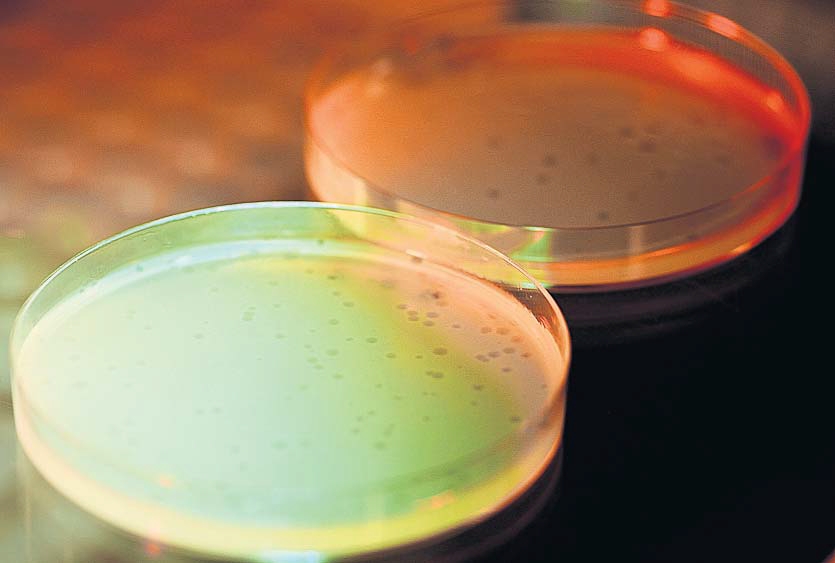

Abstract
The realisation of a circular economy has thus far unfolded under the assumption that it would fit within existing economic arrangements. In practice, we witness many circular initiatives struggling to give shape to their ambitions, let alone develop to maturity. These past months, various material recycling organisations terminated their activities, seeing virgin alternatives from other parts of the world flooding the market at prices against they cannot compete. If the transition towards a circular economy (i.e. an economy of value preservation) is to be taken seriously, a new perspective on value in our economic system seems unavoidable, as the rewriting of the rules of the economic game. At this moment, current perceptions of value stand in the way of this transition both at micro as well as macro levels. Several contours for a collective exploration of new directions of value and economic configuration that foster circular transition will be addressed.
Abstract
In his key note he will conclude after a life of innovations that it is impossible that humanity will stay within the save planetary boundaries with innovation only. We should be more critical about the behaviour of the rich population in the world and more critical about new innovations that prove to be dangerous, like the PFAS crisis shows at this moment. In his keynote he will investigate how to look at the world that can stay within the save planetary boundaries, how should we change ourselves? It is clear if we only talk about the words of science and systems we miss the essential words of how we should cooperate and change ourselves. And his search for coherent save innovations. Which innovations will be save and will lead to a fair and sustainable world? And will lead to a world we want to live in.
Abstract
There is a growing number of new sustainable, inclusive, cohesive, participatory, just and humane economic models. A possible next step in the discourse about them is the comparative analysis in order to find out key commonalities, potential synergies, and “requirements” for a future-fit economic model. The author and initiator of the Economy for the Common Good provides an overview of these „new sustainable economic models“ and compares them according to underlying values, principles, and practical ways of implementation. The keynote addresses the cooperative spirit of the conference and prepares the ground for its public highlight on the eve of June 3rd, the round table with representatives of diverse future-fit economic models.
Abstract
The scientific debate on whether economies should always continue to grow increasingly becomes a political and societal debate. On the one hand further growth for the most affluent countries seems neither possible nor valuable, but on the other hand there is still lack of understanding and knowledge what a non-growing economy should look like and could best be governed. In this lecture we discuss various policy measures that can be realistically implemented, take into account government finances and aim at a higher quality of life despite a non-growing economy.
Abstract
Democracy is under pressure, and less and less able to stir the economy into a sustainable direction. Therefore, to stabilize democracy and to make possible the socio-ecological transformation of the economy, democratic principles need to be implemented directly in the economy. This is not only a matter of morality, but also has practical advantages. Democratizing the economy can increase legitimacy and take advantage of the “knowledge of the many” to accelerate the transformation. Democratic practices, especially deliberation, allow bringing together different forms of knowledge, which is crucial for the local implementation of principles of social and ecological sustainability. This talk explores what this idea means in more concrete terms, from democratic participation in the workplace to the democratization of time.
Abstract
Over the past decades, markets have conventionally been seen as the best instrument to stimulate economic growth and enhance prosperity and well-being. The automatic link between markets and economic growth is increasingly questioned, however, as well as the automatic link between economic growth and enhancement of well-being. This has led to attempts to capture well-being development more directly than through GDP per capita figures and has produced a more variegated picture of well-being growth. Also, this has led to a shift of focus to other coordination systems than the market, as primarily the state but increasingly also the association. Analyses of the historical record suggest that especially the latter could be a vital component in future well-being.



